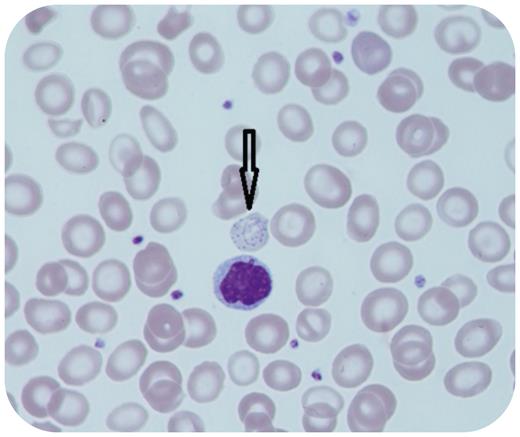
graphic

A peripheral blood smear was obtained from a 74-year-old man with anemia, new onset thrombocytopenia, and monocytosis. The anemia had existed for at least 3 years. Microscopic investigation revealed slightly left-shifted granulopoiesis with 2% band forms and 2% metamyelocytes. In addition, ring-shaped inclusions were detected in erythropoietic cells and identified as Cabot rings (100× objective) accompanied by basophilic staining, suggesting ineffective erythropoiesis. The granulopoiesis appeared dysplastic with enlarged and hypogranular cells, which is typical for chronic myelomonocytic leukemia. Consecutive bone marrow puncture offered a concordant picture with trilineage dysplasia and 9% promonocytes/blasts that established the diagnosis of chronic myelomonocytic leukemia. The molecular genetic and cytogenetic profile showed SF3B1, CBL, 2x TET2, and TP53 mutations and a loss of the Y chromosome in all metaphases.
Cabot rings represent microtubules that remain from the mitotic spindle apparatus in erythropoietic cells. Therefore, Cabot rings are an expression of significant alterations of erythropoiesis that might indicate hematological neoplasms such as acute myeloid leukemia, chronic myeloid leukemia, myelodysplastic syndrome, or chronic myelomonocytic leukemia. Serious benign diseases such as severe vitamin B12 deficiency or lead poisoning are the most frequently reported causes associated with Cabot rings.
For additional images, visit the ASH Image Bank, a reference and teaching tool that is continually updated with new atlas and case study images. For more information, visit https://imagebank.hematology.org.
This feature is available to Subscribers Only
Sign In or Create an Account Close Modal